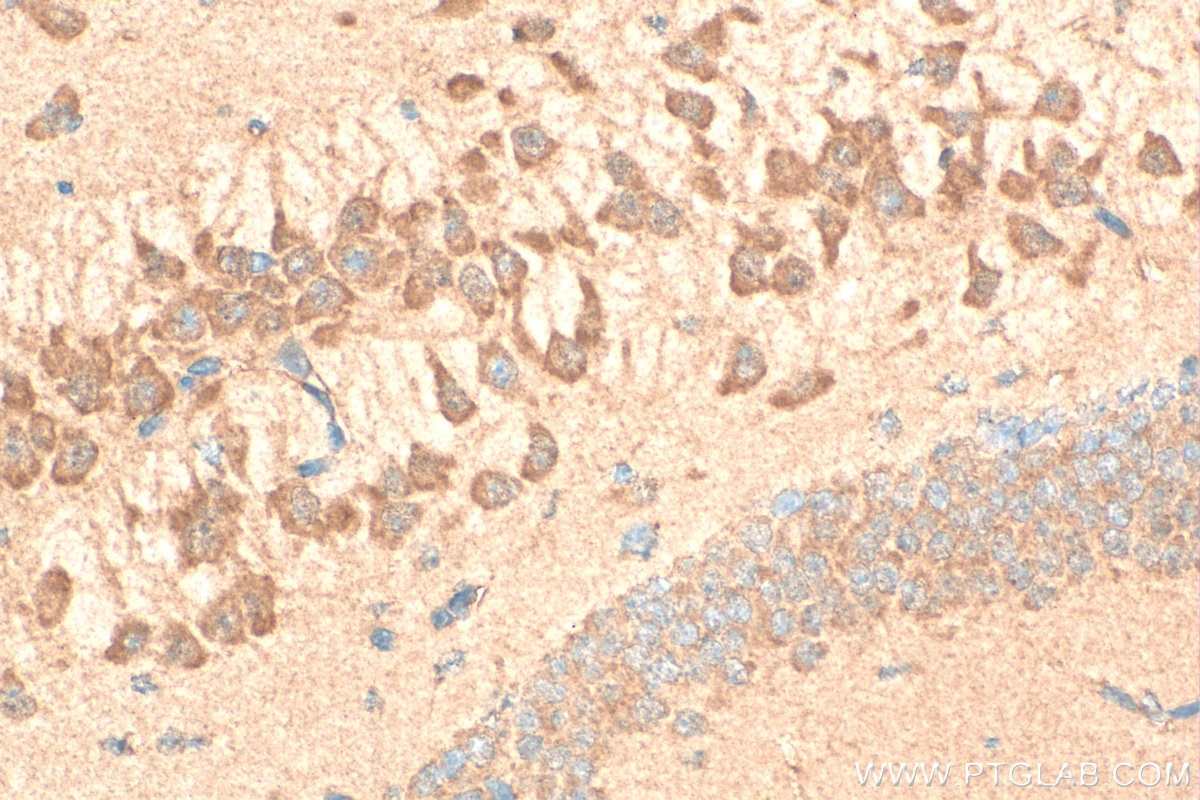
Immunohistochemical analysis of paraffin-embedded mouse brain tissue slide using 12979-1-AP (GABRA4 antibody) at dilution of 1:200 (under 40x lens). Heat mediated antigen retrieval with Tris-EDTA buffer (pH 9.0). Immunohistochemistry (IHC) staining of mouse brain tissue using GABRA4 Polyclonal antibody (12979-1-AP)

Tested Applications
| Positive WB detected in | mouse skeletal muscle tissue, mouse brain tissue, human kidney tissue, mouse kidney tissue |
| Positive IP detected in | mouse skeletal muscle tissue |
| Positive IHC detected in | mouse brain tissue Note: suggested antigen retrieval with TE buffer pH 9.0; (*) Alternatively, antigen retrieval may be performed with citrate buffer pH 6.0 |
Recommended dilution
| Application | Dilution |
|---|---|
| Western Blot (WB) | WB : 1:500-1:3000 |
| Immunoprecipitation (IP) | IP : 0.5-4.0 ug for 1.0-3.0 mg of total protein lysate |
| Immunohistochemistry (IHC) | IHC : 1:50-1:500 |
| It is recommended that this reagent should be titrated in each testing system to obtain optimal results. | |
| Sample-dependent, Check data in validation data gallery. | |
Published Applications
| WB | See 3 publications below |
| IP | See 1 publications below |
Product Information
12979-1-AP targets GABRA4 in WB, IHC, IP, ELISA applications and shows reactivity with human, mouse, rat samples.
| Tested Reactivity | human, mouse, rat |
| Cited Reactivity | human, mouse |
| Host / Isotype | Rabbit / IgG |
| Class | Polyclonal |
| Type | Antibody |
| Immunogen |
CatNo: Ag3600 Product name: Recombinant human GABRA4 protein Source: e coli.-derived, PGEX-4T Tag: GST Domain: 338-554 aa of BC035055 Sequence: AAVNYFTNIQMEKAKRKTSKPPQEVPAAPVQREKHPEAPLQNTNANLNMRKRTNALVHSESDVGNRTEVGNHSSKSSTVVQESSKGTPRSYLASSPNPFSRANAAETISAARALPSASPTSIRTGYMPRKASVGSASTRHVFGSRLQRIKTTVNTIGATGKLSATPPPSAPPPSGSGTSKIDKYARILFPVTFGAFNMVYWVVYLSKDTMEKSESLM Predict reactive species |
| Full Name | gamma-aminobutyric acid (GABA) A receptor, alpha 4 |
| Calculated Molecular Weight | 554 aa, 62 kDa |
| Observed Molecular Weight | 62-70 kDa |
| GenBank Accession Number | BC035055 |
| Gene Symbol | GABRA4 |
| Gene ID (NCBI) | 2557 |
| RRID | AB_2108996 |
| Conjugate | Unconjugated |
| Form | Liquid |
| Purification Method | Antigen affinity purification |
| UNIPROT ID | P48169 |
| Storage Buffer | PBS with 0.02% sodium azide and 50% glycerol, pH 7.3. |
| Storage Conditions | Store at -20°C. Stable for one year after shipment. Aliquoting is unnecessary for -20oC storage. 20ul sizes contain 0.1% BSA. |
Background Information
Gamma-aminobutyric acid (GABA) is the major inhibitory neurotransmitter in the mammalian brain where it acts at GABA-A receptors, which are ligand-gated chloride channels. Chloride conductance of these channels can be modulated by agents such as benzodiazepines that bind to the GABA-A receptor. GABRA4, encoding the extrasynaptically located α4‐subunit of the GABAA receptor, is involved in the etiology of autism. (PMID: 32028044, 32033586)
Protocols
| Product Specific Protocols | |
|---|---|
| IHC protocol for GABRA4 antibody 12979-1-AP | Download protocol |
| IP protocol for GABRA4 antibody 12979-1-AP | Download protocol |
| WB protocol for GABRA4 antibody 12979-1-AP | Download protocol |
| Standard Protocols | |
|---|---|
| Click here to view our Standard Protocols |
Publications
| Species | Application | Title |
|---|---|---|
FASEB J Electro-acupuncture alleviates adolescent cocaine exposure-enhanced anxiety-like behaviors in adult mice by attenuating the activities of PV interneurons in PrL. | ||
Cell Mol Life Sci Cyclin D1-Cdk4 regulates neuronal activity through phosphorylation of GABAA receptors | ||
Genes Dis The Traf2 and NcK interacting kinase inhibitor NCB-0846 suppresses seizure activity involving the decrease of GRIA1 |